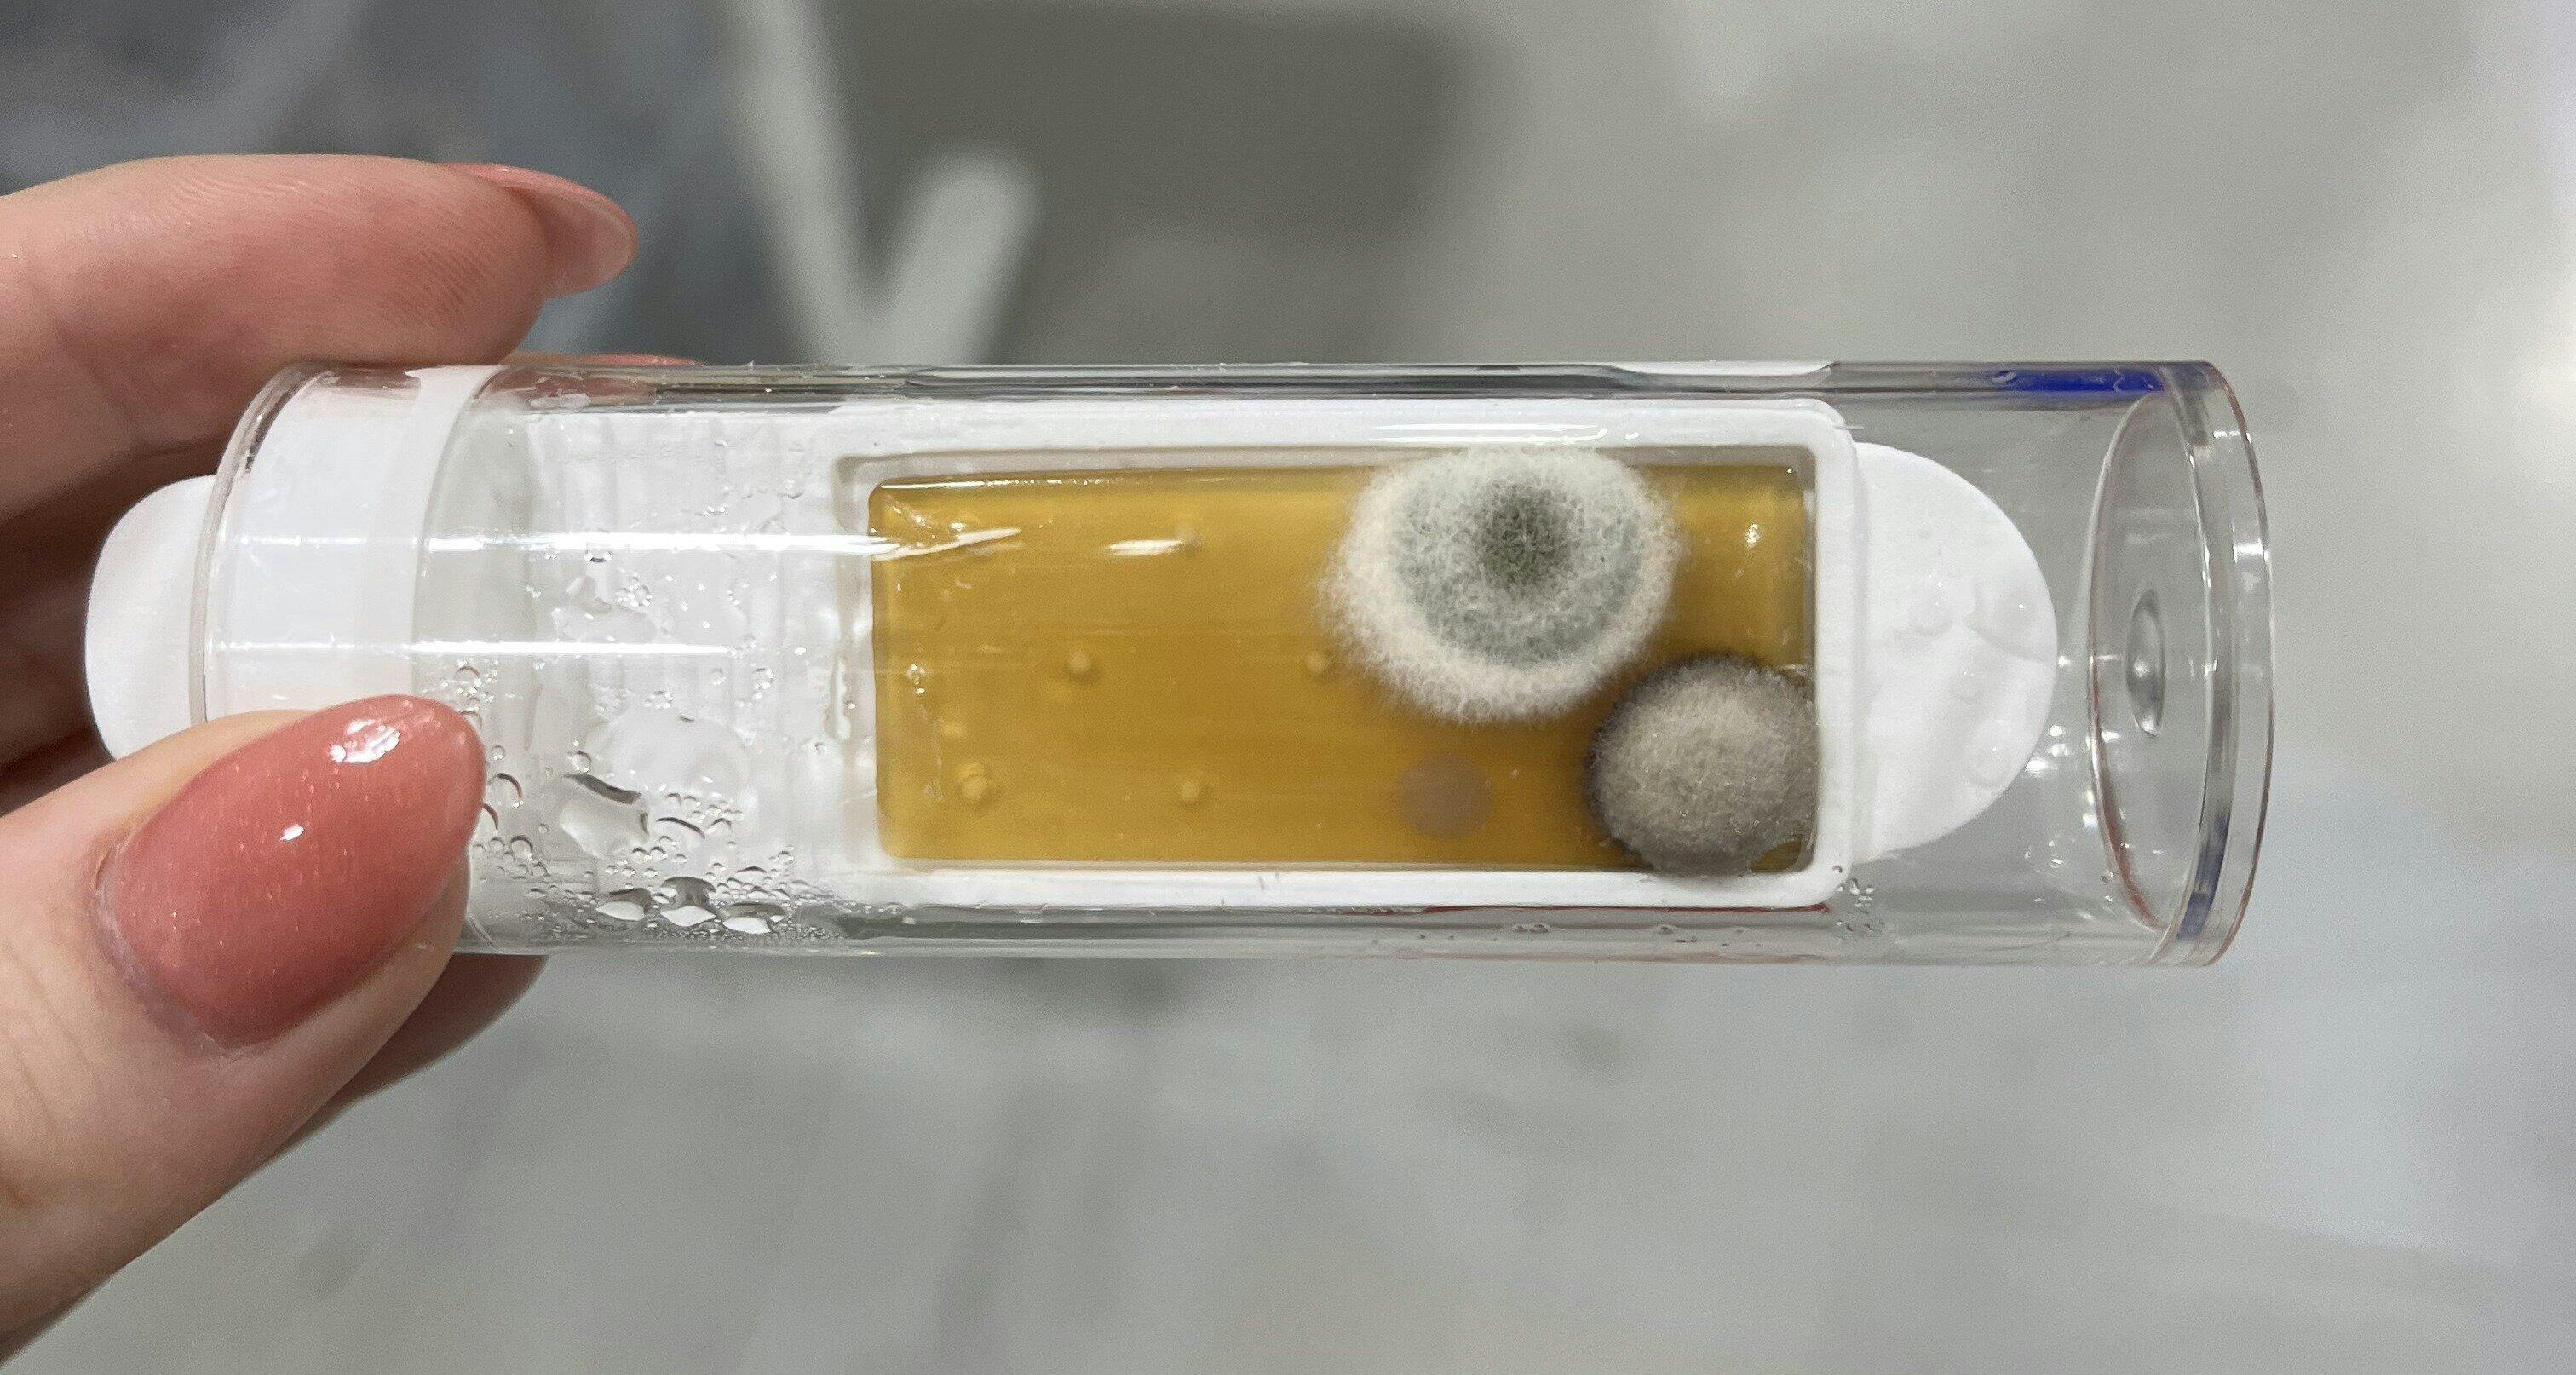

Mold & Indoor Air Quality Test Kit 6 Locations
Mold & Indoor Air Quality Test Kit 6 Locations
Couldn't load pickup availability
What do I test?
What do I test?
SEE INVISIBLE DANGERS: Detect the presence of bacteria, mold, and fungus that may linger even after cleaning—especially in high-touch or moisture-prone areas. Unlike many kits that offer a simple yes/no result, our test shows the amount of bacteria AND mold present—giving you a visual indicator of exposure risk.
Test for bacteria, mold, and fungus on surfaces, appliances, drinking water, and more. Know species AND how bad the problem is, with semi-quantitative results.
How does it work?
How does it work?
Check the effectiveness of your cleaning routine or products on key surfaces like fridge handles, cutting boards, doorknobs, and more. Mold in your fridge water track – test the water too!
Backed by Detekt’s lab-grade technology used around the world for over 20 years, this DIY kit brings professional-quality testing into your home with no mailing or lab analysis required.
View Detailed Guides & Instructions Videos
More about mold testing
More about mold testing
>> >> Check out our knowledge hub with dozens of articles on mold testing!
Your home may look clean, but dangerous microbes can be invisible to the eye. Molds such as Fusarium and Aspergillus. The Detekt Home Mold Test Kit empowers you to detect microbial presence before it affects your family’s health.
Built on over 20 years of expertise in professional microbial testing, used by the EPA, WHO, FDA, and USDA, our kit transforms industrial-grade science into a simple, family-friendly tool.
- Dual Detection: Identifies both harmful bacteria and mold in one test.
- Lab-Grade Accuracy at Home: Proven technology trusted in industrial and regulatory standard.
- Peace of Mind in Minutes: Easy step-by-step use with clear, visual results.
- Family-First Innovation: Developed by a family business committed to protecting homes worldwide.
This lab-grade DIY mold test kit helps you detect mold, bacteria, and fungus in your home with visual results in 72 hours. Made in the USA and designed for at-home use, it gives you a practical first step when you notice musty odors, water damage, or allergy-triggering spots. Unlike kits that require added lab fees just to get started, this one gives you fast visual screening and access to expert consultation.
- 6-piece home testing kit for checking indoor surfaces and problem areas
- Visual mold growth results in as little as 72 hours
- Detects mold, bacteria, and fungus in common household environments
- Made in USA with lab-grade testing components
- No lab fees for the core DIY screening process
- Includes expert consultation for added guidance
Use it in bathrooms, basements, kitchens, laundry rooms, around windows, near HVAC vents, or anywhere you have condensation, leaks, or past flooding. Compared to guessing based on smell or visible stains alone, this kit gives you a clearer way to confirm whether microbial growth may be present.
It is a solid fit for renters, homeowners, parents, and anyone checking indoor air and surface concerns after moisture issues. If you want a straightforward mold screening tool with a measurable turnaround time and no extra lab fee barrier, this 6-piece kit makes home testing easier.
Before sampling

After 48-72 hours


Frequently Asked Questions
Do mold testing kits really work?
What is the most accurate home mold test kit?
How long does it take to get results from this mold test kit?
What does the 6-piece kit include, and how many areas can I test?
Can this kit detect mold, bacteria, and fungus in the home?
Do I have to send the test to a lab or pay lab fees?
Who should use a DIY mold test kit at home?
Can I use this kit after water damage or a leak?
What are the warning signs that I should test my home for mold?
What level of mold is considered unsafe or uninhabitable?
What organisms does this test detect?
What organisms does this test detect?
The kit is designed to indicate the presence of bacteria (such as coliforms and E. coli) and common toxic and benign molds (such as Aspergillus or Stachybotrys).
Do I need special equipment? Or lab testing?
Do I need special equipment? Or lab testing?
No, everything you need is included in the kit. No lab required.
How fast are results?
How fast are results?
Most tests show visible results within 24–72 hours.
What if I get a positive result?
What if I get a positive result?
A positive indicates possible microbial contamination or unseen mold growth in the area sampled.
How do I test for mold in my home without a professional?
How do I test for mold in my home without a professional?
Our DIY mold test kit makes home testing simple. Just collect an air or surface sample, wait for results to develop, and compare to the visual guide. You'll see both mold and bacteria levels in minutes—no lab fees, no mailing, no waiting weeks for answers. It's the same technology trusted by EPA professionals, now available for families.
What types of mold does this home mold test kit detect?
What types of mold does this home mold test kit detect?
The Detekt mold test kit detects a wide range of harmful mold species including Aspergillus, Fusarium, Penicillium, and other common household molds. Unlike basic yes/no tests, our kit shows you how much mold is present with semi-quantitative results—so you know if it's a minor issue or a serious concern requiring action.
When should I test my home for mold and bacteria?
When should I test my home for mold and bacteria?
Test your home for mold when you notice musty odors, visible moisture, water damage, or after flooding. Regular testing is recommended for high-risk areas like bathrooms, basements, kitchens, and HVAC systems. Families with allergies, asthma, or young children should test more frequently. Our mold test for home makes routine monitoring quick and affordable.
Is the Detekt mold test kit safe and easy for families to use?
Is the Detekt mold test kit safe and easy for families to use?
Absolutely! The Detekt mold test kit is designed specifically for families—no technical expertise required. The simple visual results make it easy to understand your home's mold and bacteria levels at a glance. Developed by a family-owned business in Austin, TX, and made in the USA, our kit gives you peace of mind knowing exactly what's in your home's air.